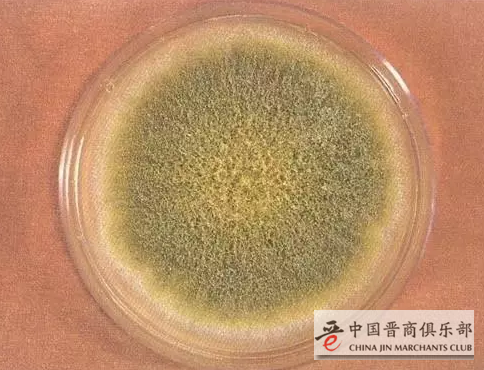

有毒!黄曲霉毒素,是一种毒性极强的剧毒物质,其毒性是砒霜的68倍,是氰化钾的10倍,对肝脏组织的破坏性极强!
致癌!它还是我们所知的最强的生物致癌剂之一,少量就能致癌!1993年,它就被世界卫生组织(WHO)的癌症研究机构划定为1类致癌物。
最让人无奈的是,这种剧毒致癌物就存在于我们的日常生活中!
小心!
这些食物里都藏着黄曲霉素
1、一颗花生发霉,最好一包都扔掉

黄曲霉素最喜欢藏在发霉的食物里,尤其是淀粉含量高的食物,花生也不例外,在高温湿润的环境下,最容易滋生这种致癌霉菌。
注意:如果有一颗花生霉变,整包花生最好都要扔掉。黄曲霉菌是以孢子形式传播的,食物极易牵连霉变。
2、发苦的坚果

如果吃到变苦的瓜子、杏仁等坚果,一定要及时吐掉并且漱口,因为瓜子等坚果的苦味正是来自霉变过程中产生的黄曲霉毒素,经常食入会增加肝癌风险。
建议: 吃到霉变的、发苦的坚果千万别犯懒,一定要马上吐出来。
3、泡了好几天的木耳

曾有这样的新闻:浙江瑞安的一名消费者因吃了泡了三天的黑木耳致食物中毒,导致多脏器功能衰竭,生命垂危。医生给出的就诊结果是微生物毒素造成的后续严重后果。木耳泡发中会产生黄曲霉毒素等。
建议:木耳吃多少泡多少,不要浸泡好几天。
4、没洗干净的筷子

筷子本身并不会长黄曲霉菌,但平时用筷子吃玉米、花生等淀粉含量高的食物时筷子里易藏淀粉,时间长了导致霉变而产生黄曲霉毒素。裸筷子、漆筷子极易开裂藏食物残渣而产生黄曲霉毒素。
建议:
1、最佳选择是铁筷子,很难出裂痕,也就不会有食物残渣。
2、平时洗筷子的时候要记得先泡一泡,软化上面的食物残渣,以便容易清洗掉。
5、发霉的玉米

黄曲霉毒素藏在发霉的食物里,尤其是淀粉含量高的花生、玉米、豆类等食物,淀粉在高温和潮湿的环境下会滋生导致肝癌的黄曲霉毒素。
建议:每次少买点,不要“存”,以免霉变。
6、小作坊自榨油

一般小作坊的压榨机或家用榨油机工艺简单,没有除去有害物质工艺,不能对原材料进行精炼,所以对去壳的外表正常内部已出现黄曲霉毒素的花生是挑不出来的。而且原料发霉,榨得的油中还可能带入黄曲霉毒素。
建议:去大超市购买知名品牌。

怎么办?
如何让黄曲霉素远离我们
有人说,我在锅里好好地蒸煮食物不就可以“消毒”了?
可是,还真不是这样的!一般烹调加工温度不能将黄曲霉素破坏,因为黄曲霉素裂解温度为280℃。只有达到280℃的时候,才能灭活,一般的烹饪方法都不能消毒。连消毒碗柜都不行,黄曲霉素对紫外线有抵抗力。
怎么办?除了前文提到的几个建议,专家提供了两个小技巧:

1、油热了先加盐
做菜之前的一个小动作就能帮消除一定量的黄曲霉素。如果我们在花生油等食用油倒入锅里加热后,并放入少量食盐,搅拌10~20秒,这样基本上就能消除大部分的食用油里的黄曲霉素。食盐对黄曲霉素的中和和降解,大概能消除95%的黄曲霉素。
2、多吃点绿叶蔬菜
多吃绿叶蔬菜可以让我们平时不小心吃下去的黄曲霉素失效一部分,因为叶绿素能够阻止黄曲霉素吸收,预防肝癌。






































